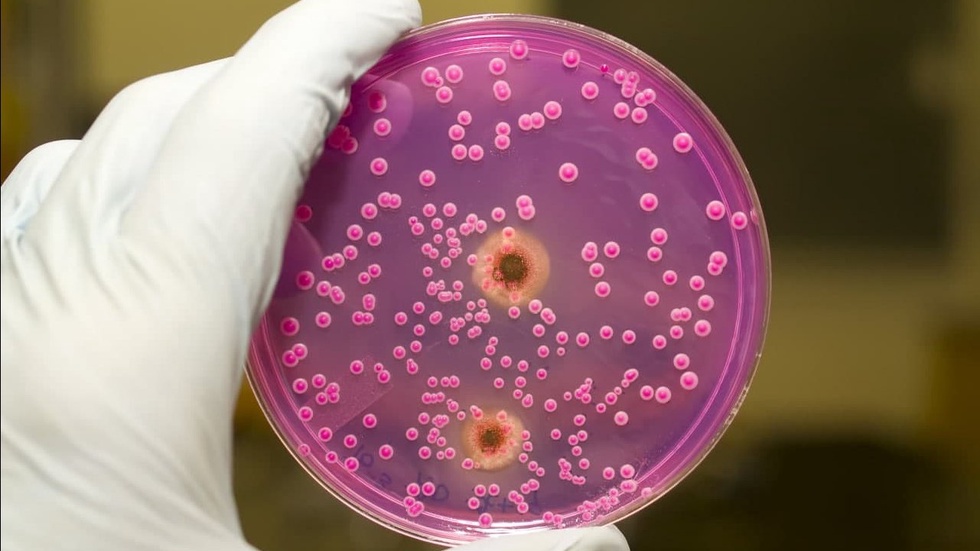

Ана шундай замбуруғлар сабаб организмда ривожланадиган касалликлар ҳақидаги саволларга Республика ихтисослаштирилган дерматология ва косметология илмий-амалий тиббиёт маркази директор ўринбосари Илҳом Раҳимов жавоб берди.
— Касаллик чақирувчи замбуруғлар инсон организмига қандай ўтади?
— Замбуруғларнинг 100 000 дан ортиқ турлари маълум бўлиб, улардан 500 тага яқини одам ва ҳайвонлар учун патоген ҳисобланади, яъни касаллик пайдо қилади. Замбуруғли касалликлар бемордан ёки касал ҳайвондан одамга (асосан, бемор билан бевосита мулоқотда бўлганда ёки унинг зарарланган буюмларидан фойдаланганда) ўтади.
Улар ташқи муҳитнинг турли омилларига чидамли, масалан, очиқ сув ҳавзалари, ўрин-кўрпалар, кийим-бош, гилам ҳамда сочларга тушганда бир неча йилгача касаллик чақириш қобилиятини сақлаб қолади.
Атроф-муҳит ҳолати (экология) бузилиши, турли хил дори воситалари (антибиотиклар, цитостатиклар, стероидли гормонлар) пала-партиш, юқори миқдорда ёки узоқ муддат қабул қилиниши ёки оғир кечувчи йўлдош касалликлар (ўсма, қандли диабет ва бошқалар) мавжудлиги кўпинча замбуруғли касалликлар келиб чиқишини тезлаштиради.
Бундай омиллар таъсирида организм иммун тизими фаолияти сусаяди ва замбуруғларнинг кўпайиши учун қулай шароитлар яратилади.
— Замбуруғлар сабабли ривожланувчи касалликларнинг қандай турлари бор?
— Замбуруғларнинг ачитқисимон тури патоген ҳисобланади. Улар (кандида замбуруғлари) табиатда жуда кенг тарқалган бўлиб, мева-сабзавот, сут маҳсулотлари, шунингдек, одам, ҳайвон териси ҳамда шиллиқ қаватларда сапрофит ҳолатда яшайди ва фақат муайян шароитларда кандидозлар деб аталувчи ўзига хос касалликни келтириб чиқаради. Меъда-ичак хасталиклари, витаминлар мувозанатининг бузилиши, лейкоз касаллиги, антибиотиклар билан тартибсиз даволаниш кандида замбуруғларининг фаолиятини ошириб, касаллик вужудга келишига олиб келади.
Касалликнинг клиник кечишига қараб:
- шиллиқ қават ва тери кандидози,
- кандидозли онихомикоз,
- паронихомикоз,
- сурункали генерализациялашган болалар кандидози алоҳида ажратилади.
Бунда бемор танасида тўқ қизил рангли, аниқ чегараланган, усти гардиш билан қопланган доғлар пайдо бўлади. Бармоқлар орасидаги кандидозли эрозия асосан қандолатчилар, идиш-товоқ ювувчилар ва бошқаларда учрайди.
Жараён 3-, 4-бармоқлар орасида, тўқ қизил рангли, аниқ чегараланган ва ўртасида сероз суюклик бўлган эрозия борлиги билан ифодаланади.
Оғиз шиллиқ қавати кандидози эса ташқаридан кириб келган замбуруғ ҳисобига ривожланиши мумкин.
Мутахассис билан суҳбатни Соғлиқни сақлаш вазирлиги матбуот хизмати олиб борди.